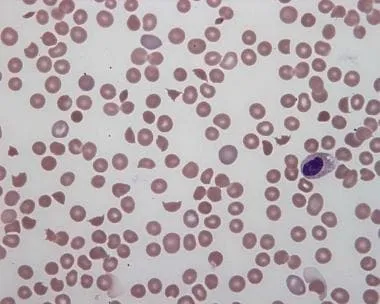
Peripheral blood smear showing schistocytes in HUS

E. coli Basics - The Gutsy Gram-Negative
- Morphology: Gram-negative rod, facultative anaerobe.
- Habitat: Normal commensal of the GI tract; however, pathogenic strains cause a wide range of diseases.
- Key Biochemical Markers:
- Lactose fermenter → forms pink colonies on MacConkey agar.
- Catalase-positive, Oxidase-negative.
- Indole-positive.
- Antigenic Structure: Serotyped by O (somatic), H (flagellar), and K (capsular) antigens.
⭐ E. coli is the #1 cause of urinary tract infections (UTIs) and gram-negative sepsis.

Extraintestinal Disease - Beyond the Bowel
- Urinary Tract Infection (UTI): The most common cause of both community and hospital-acquired UTIs.
- Uropathogenic E. coli (UPEC) utilize P fimbriae for adhesion to the urothelium, preventing washout.
- Neonatal Meningitis: A leading cause, second only to Group B Strep.
- Strains possessing the K1 capsular antigen are typically responsible.
- Sepsis: LPS endotoxin in the outer membrane can trigger septic shock, often secondary to a UTI or intra-abdominal infection.
⭐ E. coli is the number one cause of urinary tract infections.

Diarrheagenic Strains - A Tale of Tummy Troubles

- A comparative overview of key E. coli strains causing gastroenteritis.
| Strain | Pathogenesis | Clinical Features | Notes |
|---|---|---|---|
| ETEC | Traveler's Diarrhea | Profuse watery diarrhea | Toxins: Heat-Labile (LT → ↑cAMP), Heat-Stable (ST → ↑cGMP) |
| EPEC | Pediatric Diarrhea | Watery diarrhea, malabsorption | Adherence/effacement of microvilli in the small intestine. |
| EHEC | Hemorrhagic Colitis | Bloody diarrhea, severe cramps | O157:H7 serotype. Produces Shiga-like toxin. No fever. |
| EIEC | Invasive | Bloody diarrhea, fever, pus | Invades large intestine mucosa; clinically similar to Shigella. |
⭐ EHEC (O157:H7) can cause Hemolytic Uremic Syndrome (HUS): triad of anemia, thrombocytopenia, and acute renal failure. Avoid antibiotics as they can ↑ HUS risk.
EHEC & HUS - Bloody Business
- Source: Undercooked ground beef, unpasteurized milk, raw leafy greens.
- Toxin: Shiga-like toxin (verotoxin) halts protein synthesis by inactivating the 60S ribosomal subunit.
- Presentation: Bloody, voluminous diarrhea (dysentery) with abdominal pain, but typically no fever.
- ⚠️ Warning: Antibiotics are contraindicated; they can induce toxin release and ↑ risk of HUS.
⭐ E. coli O157:H7 is the most common serotype; it is distinguished from other E. coli by not fermenting sorbitol on MacConkey agar.
Diagnosis & Treatment - Lab Coat & Rx
- Lab Diagnosis
- Culture: Lactose-fermenter on MacConkey agar (pink colonies) & classic green metallic sheen on Eosin Methylene Blue (EMB) agar.
- Indole positive (distinguishes from Klebsiella).

- Treatment (Rx)
- UTI: TMP-SMX, nitrofurantoin, fosfomycin.
- Systemic/Sepsis: 3rd-gen cephalosporins (e.g., ceftriaxone).
- EHEC: Supportive care. ⚠️ Antibiotics may ↑ HUS risk.
⭐ EHEC (O157:H7) is unique as it does not ferment sorbitol on Sorbitol-MacConkey (SMAC) agar, appearing as colorless colonies.
High‑Yield Points - ⚡ Biggest Takeaways
- #1 cause of Urinary Tract Infections (UTIs) and a common trigger for gram-negative sepsis.
- Lactose-fermenting gram-negative rod that grows pink on MacConkey agar.
- ETEC causes watery "Traveler's Diarrhea," while EHEC (O157:H7) causes bloody diarrhea and Hemolytic Uremic Syndrome (HUS).
- EHEC's Shiga-like toxin inactivates the 60S ribosome, causing endothelial damage.
- A primary cause of neonatal meningitis.
- Virulence is driven by pili for UTI attachment and LPS endotoxin causing septic shock.
Unlock the full lesson and continue reading
Signup to continue reading this lesson and unlimited access questions, flashcards, AI notes, and more